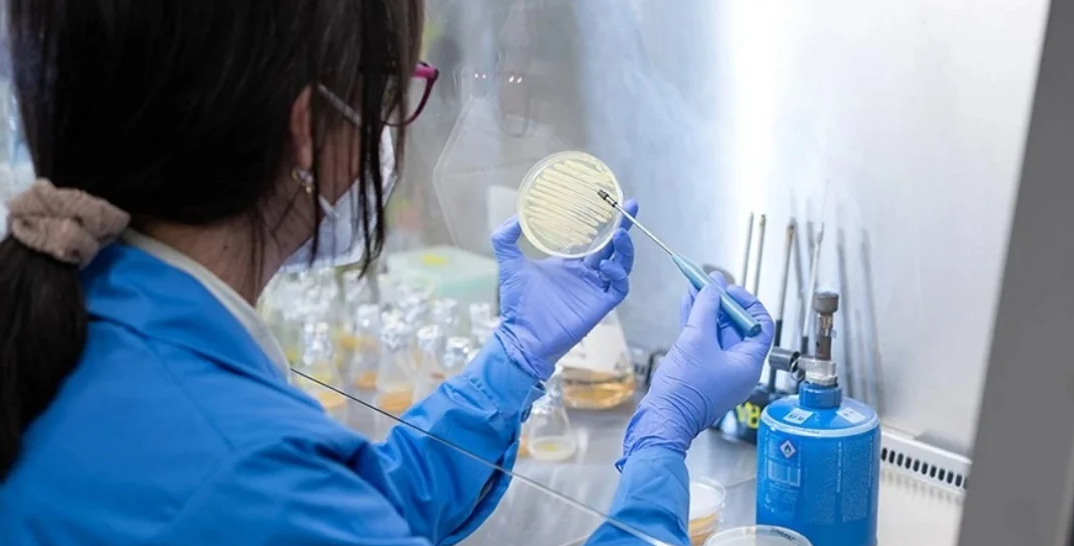

El proyecto Phasal busca avanzar en el mundo de la medicina con la creación de nuevos bioplásticos biodegradables a partir de residuos agroalimentarios. Estos materiales están diseñados para aplicaciones médicas de alto valor añadido, como parches transdérmicos y equipos de sutura.
¿Cómo logran esto?
Phasal se centra en desarrollar nuevos grados de plásticos biodegradables, PHA, a partir de la valorización de residuos orgánicos. Estos nuevos materiales no solo contarán con propiedades avanzadas de procesabilidad y biocompatibilidad, sino que también se enfocarán en aplicaciones en las que las opciones de reciclaje son limitadas.
Para garantizar la eficacia de estos bioplásticos, se pretende implementar una metodología para determinar su biodegradabilidad. De manera acelerada, se espera ayudar en el desarrollo de nuevos materiales biobasados.
La importancia de este proyecto radicó en los retos medioambientales que enfrenta el sector sanitario, donde más de 50% del plástico utilizado es de un solo uso debido a las exigencias de higiene y esterilización. Con estos nuevos bioplásticos, se busca ofrecer soluciones sostenibles y responsables que puedan beneficiar a las generaciones futuras.
Según Germán Perez, responsable del departamento de VEomaterial en VEnvirotech:
Phasal es un proyecto pionero que representa un hito significativo en la convergencia entre la industria y la investigación en el ámbito de la salud. VEnvirotech está ejerciendo un papel crucial al proporcionar soluciones innovadoras y sostenibles para dos casos de productos distintivos.
El proyecto se llevará a cabo en colaboración con VEnvirotech Biotecnology, Industria Técnica del Plástico, Inteplast, Eurecat y el grupo de investigación Psep, Polímeros Sintéticos: Estructura y Propiedad. Polímeros Biodegradables, de la Universitat Politècnica de Catalunya. Con un presupuesto de más de EUR$800.000, el proyecto se desarrollará durante 3 años, financiado por la convocatoria de “Proyectos de Colaboración Público- privada.
Tomado del Repositorio Agronegocios de la Revista La República.